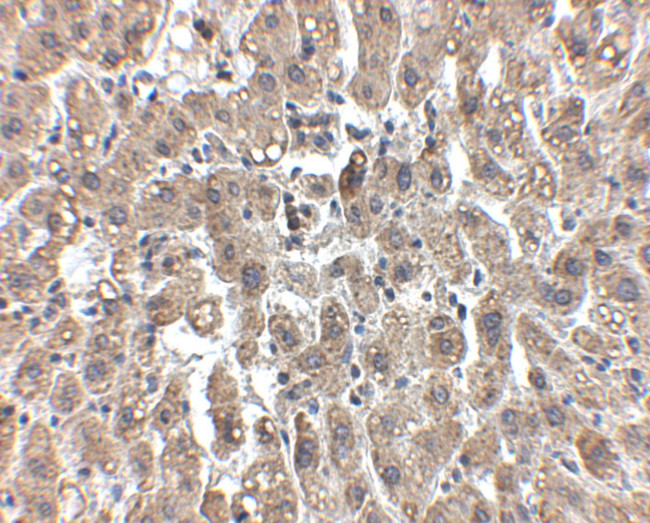
LDLR Antibody in Immunohistochemistry (IHC)

Search
Invitrogen
LDLR Polyclonal Antibody
{{$productOrderCtrl.translations['antibody.pdp.commerceCard.promotion.promotions']}}
{{$productOrderCtrl.translations['antibody.pdp.commerceCard.promotion.viewpromo']}}
{{$productOrderCtrl.translations['antibody.pdp.commerceCard.promotion.promocode']}}: {{promo.promoCode}} {{promo.promoTitle}} {{promo.promoDescription}}. {{$productOrderCtrl.translations['antibody.pdp.commerceCard.promotion.learnmore']}}





Please note: We are reviewing Western blot images included in the antibody testing data in our catalog, including those provided by third parties. Unless expressly labeled or annotated as “raw-unedited”, Western blot images included in the antibody testing data in our catalog may have been edited, optimized or otherwise adjusted for presentation.
产品信息
PA5-20752
种属反应
宿主/亚型
分类
类型
抗原
偶联物
形式
浓度
规格
纯化类型
保存液
内含物
保存条件
运输条件
RRID
产品详细信息
A suggested positive control is human liver tissue lysate.
PA5-20752 can be used with blocking peptide PEP-0866.
靶标信息
The low density lipoprotein receptor (LDL-R) gene family consists of cell surface proteins involved in receptor-mediated endocytosis of specific ligands. Low density lipoprotein (LDL) is normally bound at the cell membrane and taken into the cell ending up in lysosomes where the protein is degraded and the cholesterol is made available for repression of microsomal enzyme 3-hydroxy-3-methylglutaryl coenzyme A (HMG CoA) reductase, the rate-limiting step in cholesterol synthesis. At the same time, a reciprocal stimulation of cholesterol ester synthesis takes place. Mutations in the LDL-R gene cause the autosomal dominant disorder, familial hypercholesterolemia. Along with SCARB1, CLDN1, and the tetraspanin superfamily member CD81, LDL-R has been reported to be an entry factor for the Hepatitis C virus. At least three isoforms of LDL-R are known to exist.
仅用于科研。不用于诊断过程。未经明确授权不得转售。
篇参考文献 (0)
生物信息学
蛋白别名: LDL receptor; ldl-r; Low-density lipoprotein receptor
基因别名: Hlb301; Ldlr; LDLRA
UniProt ID: (Mouse) P35951, (Rat) P35952
Entrez Gene ID: (Mouse) 16835, (Rat) 300438